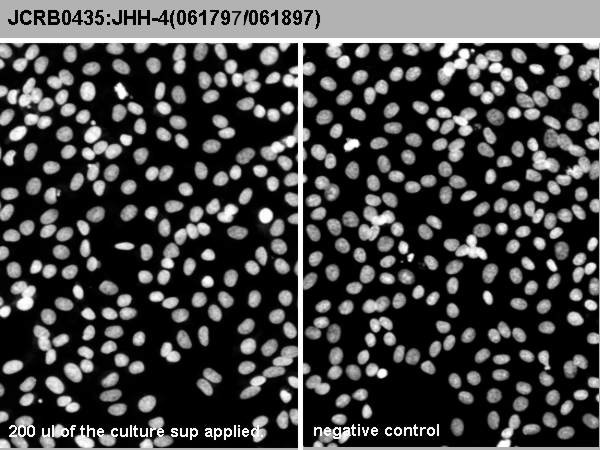

JCRB0435 JHH-4
細胞情報
Important Notice(s)On the agreement for distribution of JHH series cell lines, NOZ and OZ
細胞種類:一般細胞 (細胞分譲手数料はこちら)
| 細胞番号(JCRB) | JCRB0435 | 細胞名 | JHH-4 |
|---|---|---|---|
| 生物種(日本語) | ヒト | 組織名(日本語) | 肝臓, 胆嚢 |
| コメント(日本語) | 肝細胞がん | プロフィール | Human hepatocellular carcinoma cell line. |
| 別名 | 動物名 | human | |
| 系統名 | 学名・属名 | Homo | |
| 学名・種小名 | sapiens | 性別 | M |
| 年齢・月齢 | 51 | 細胞識別情報 | available |
| (癌)原発組織名 | liver, gallbladder | 病歴情報 | hepatocellular carcinoma |
| 転移の有無(Y/N) | (癌)転移組織名 | ||
| 遺伝的性質 | HBV integration is not observed. | 細胞寿命 | infinite |
| クライシスPDL | 形態 | epithelial-like | |
| 一般性状 | Alpha-phetoprotein and albumin-producing cell line. HBs antigen-negative. HCV was not detected by an RT-PCR method tested in the HSRRB. | 細胞分類 | tumor |
| 細胞樹立者名 | Hasumura,S. et al. | 細胞寄託者 | Nagamori,S. |
| 分譲時制限 | Restricted: Cell's developer's approval is required | コメント | Cell Bank will handle to get the approval but the depositor may contact to the requested person directly. |
| 入手年 | 1988 | 培養培地 | Eagle's minimal essential medium with 10% fetal calf serum. |
| 継代方法 | Cells are harvested after the treatment with 0.25% trypsin and 0.02% EDTA at room temp. for 5 min. | 継代時細胞数 | 1-2x10^4 cells/sq.cm. |
| 人種 | Japanese | 炭酸ガス濃度 | 5 % |
| 採取組織名 | liver | 組織型 |
| ウイルスDNA・RNA検出検査 (Detection of virus genome fragment by Real-time PCR) | |||||||||
|---|---|---|---|---|---|---|---|---|---|
| ウイルスDNA 検出検査 |
tested | ウイルスRNA 検出検査 |
tested | ||||||
| CMV | - | parvoB19 | - | HCV | - | HTLV-1 | - | ||
| EBV | - | HBV | - | HIV-1 | - | HTLV-2 | - | ||
| HHV6 | - | HTLV-1 | - | HIV-2 | - | HAV | - | ||
| HHV7 | - | HTLV-2 | - |
-/negative. +/positive. nt/not tested. (positive (+) does not immediately mean the production of infectious viral particles.) |
|||||
| BKV | - | HIV-1 | - | ||||||
| JCV | - | HIV-2 | - | ||||||
| ADV | - | HPV18 | - | ||||||
| Notes | |||||||||
| Reference | |
|---|---|
| Pubmed id:2856444 | [Establishment and characterization of a human hepatocellular carcinoma cell line JHH-4]. Hasumura S,Sujino H,Nagamori S,Kameda H Hum Cell. 1988 Mar;1(1):98-100 |
| Research results by users. Click! | |
|---|---|
| Pubmed id:40313132 |
Cancer-Type-Specific DNA Methylation Is a Source of Vulnerability in Liver Cancer Cells. Minowa K,Seki M,Nagai Y,Yamashita S Cancer Sci. 2025 May 2;(): |
| Pubmed id:31324698 |
The 2-Hydroxyiminostilbene Metabolite of Carbamazepine or the Supernatant from Incubation of Hepatocytes with Carbamazepine Activates Inflammasomes: Implications for Carbamazepine-Induced Hypersensitivity Reactions. Kato R,Ijiri Y,Hayashi T,Uetrecht J Drug Metab Dispos. 2019 Oct;47(10):1093-1096 |
| Pubmed id:29087505 |
Editor's Highlight: An Impaired Immune Tolerance Animal Model Distinguishes the Potential of Troglitazone/Pioglitazone and Tolcapone/Entacapone to Cause IDILI. Mak A,Kato R,Weston K,Hayes A,Uetrecht J Toxicol Sci. 2018 Feb 1;161(2):412-420 |
| Pubmed id:28081667 |
Contributions of caspase-8 and -9 to liver injury from CYP2E1-produced metabolites of halogenated hydrocarbons. Ijiri Y,Kato R,Sadamatsu M,Takano M,Yasuda Y,Tanaka F,Oishi C,Imano H,Okada Y,Tanaka K,Hayashi T Xenobiotica. 2018 Jan;48(1):60-72 |
| Pubmed id:28525267 |
Supernatant from Hepatocyte Cultures with Drugs That Cause Idiosyncratic Liver Injury Activates Macrophage Inflammasomes. Kato R,Uetrecht J Chem Res Toxicol. 2017 Jun 19;30(6):1327-1332 |
| Pubmed id:27183710 |
Effect of hypoxia on UDP-glucuronosyl transferase mRNA expression in human hepatocarcinoma functional liver celL4 cell line. Kato R,Matsura A,Kamiya R,Oishi C,Kagawa Y,Tanaka F,Matsumoto N,Ijiri Y,Hayashi T Pharmazie. 2016 Mar;71(3):152-3 |
| Pubmed id:24599999 |
Novel permissive cell lines for complete propagation of hepatitis C virus. Shiokawa M,Fukuhara T,Ono C,Yamamoto S,Okamoto T,Watanabe N,Wakita T,Matsuura Y J Virol. 2014 May;88(10):5578-94 |
| Pubmed id:20044606 |
Infrequent amplification of JUN in hepatocellular carcinoma. Endo M,Yasui K,Nakajima T,Gen Y,Tsuji K,Dohi O,Zen K,Mitsuyoshi H,Minami M,Itoh Y,Taniwaki M,Tanaka S,Arii S,Okanoue T,Yoshikawa T Anticancer Res. 2009 Dec;29(12):4989-94 |
| Pubmed id:18248513 |
Chemosensitivity determinants of irinotecan hydrochloride in hepatocellular carcinoma cell lines. Takahata T,Ookawa K,Suto K,Tanaka M,Yano H,Nakashima O,Kojiro M,Tamura Y,Tateishi T,Sakata Y,Fukuda S Basic Clin Pharmacol Toxicol. 2008 Apr;102(4):399-407 |
| Pubmed id:17549407 |
Activation of a system A amino acid transporter, ATA1/SLC38A1, in human hepatocellular carcinoma and preneoplastic liver tissues. Kondoh N,Imazeki N,Arai M,Hada A,Hatsuse K,Matsuo H,Matsubara O,Ohkura S,Yamamoto M Int J Oncol. 2007 Jul;31(1):81-7 |
| Pubmed id:16041541 |
Interferon-alpha/beta upregulate IL-15 expression in vitro and in vivo: analysis in human hepatocellular carcinoma cell lines and in chronic hepatitis C patients during interferon-alpha/beta treatment. Yamaji K,Nabeshima S,Murata M,Chong Y,Furusyo N,Ikematsu H,Hayashi J Cancer Immunol Immunother. 2006 Apr;55(4):394-403 |
| Pubmed id:16522372 |
A comparison of the antitumor effects of interferon-alpha and beta on human hepatocellular carcinoma cell lines. Murata M,Nabeshima S,Kikuchi K,Yamaji K,Furusyo N,Hayashi J Cytokine. 2006 Feb 7;33(3):121-8 |
| Pubmed id:15349899 |
Proteomic signature corresponding to alpha fetoprotein expression in liver cancer cells. Yokoo H,Kondo T,Fujii K,Yamada T,Todo S,Hirohashi S Hepatology. 2004 Sep;40(3):609-17 |
| Pubmed id:10766424 |
Involvement of insulin-like growth factor binding protein-3 in the retinoic acid receptor-alpha-mediated inhibition of hepatocellular carcinoma cell proliferation. Murakami K,Matsuura T,Hasumura S,Nagamori S,Yamada Y,Saiki I Cancer Lett. 2000 Apr 3;151(1):63-70 |
| Pubmed id:9446792 |
Cyclin E overexpression responsible for growth of human hepatic tumors with p21WAF1/CIP1/SDI1. Tsuji T,Miyazaki M,Fushimi K,Mihara K,Inoue Y,Ohashi R,Ohtsubo M,Hamazaki K,Furusako S,Namba M Biochem Biophys Res Commun. 1998 Jan 14;242(2):317-21 |
| Pubmed id:8835345 |
Persistence of hepatitis C virus RNA in established human hepatocellular carcinoma cell lines. Tsuboi S,Nagamori S,Miyazaki M,Mihara K,Fukaya K,Teruya K,Kosaka T,Tsuji T,Namba M J Med Virol. 1996 Feb;48(2):133-40 |
| Pubmed id:1315167 |
Induction of allogeneic tumour- and lymphokine-activated lymphocytes against hepatocellular carcinoma. Yasumura S,Higuchi K,Hioki O,Okada K,Tsukishiro T,Tsuchida T,Miyagiwa M,Nambu S,Yasuyama T,Inoue K J Gastroenterol Hepatol. 1992 Mar-Apr;7(2):136-41 |
| Pubmed id:1651985 |
Preferential expression of the large hepatitis B virus surface antigen gene by an adenovirus-hepatitis B virus recombinant. Yuasa T,Kajino K,Saito I,Miyamura T J Gen Virol. 1991 Aug;72 ( Pt 8)():1927-34 |
| Pubmed id:1701409 |
Integration of hepatitis B virus DNA into cells of six established human hepatocellular carcinoma cell lines. Fujise K,Nagamori S,Hasumura S,Homma S,Sujino H,Matsuura T,Shimizu K,Niiya M,Kameda H,Fujita K Hepatogastroenterology. 1990 Oct;37(5):457-60 |
| Pubmed id:2543327 |
[Combination therapy of hyperthermia and other methods in liver and bile tract cancers--evaluation of these methods using cancer cell lines in vitro]. Hasumura S,Nagamori S,Fujise K,Homma S,Sujino H,Matsuura T,Shimizu K,Niiya M,Kameda H Gan To Kagaku Ryoho. 1989 Apr;16(4 Pt 2-3):1905-12 |
| Pubmed id:2856500 |
[Effects of TNF on human hepatocellular carcinoma cell lines and their modification by hyperthermia]. Hasumura S,Nagamori S,Fujise K,Homma S,Sujino H,Matsuura T,Shimizu K,Niiya M,Kameda H,Satomi N Hum Cell. 1988 Jun;1(2):238-44 |
| Pubmed id:2856444 |
[Establishment and characterization of a human hepatocellular carcinoma cell line JHH-4]. Hasumura S,Sujino H,Nagamori S,Kameda H Hum Cell. 1988 Mar;1(1):98-100 |
| Pubmed id:3428672 |
An epidemic of pseudomembranous colitis: importance of person to person spread. Nolan NP,Kelly CP,Humphreys JF,Cooney C,O'Connor R,Walsh TN,Weir DG,O'Briain DS Gut. 1987 Nov;28(11):1467-73 |
| Pubmed id:none |
THE MORPHOLOGICAL STUDY OF HUMAN CULTURED HEPATOMA CELLS BY A NEW PLASMA POLYMERIZATION REPLICA METHOD AND TEM Hajime SUJINO Jikeikai Medical Journal 33(4), 379-400 (1986) |
| Pubmed id:none |
ヒト肝癌細胞株に対するTumor necrosis factorの影響 蓮村哲 永森静志 藤瀬清隆 本間定 筋野甫 松浦知和 清水恵一郎 新谷稔 里見信子 医学のあゆみ 143(8), 655-656 (1987) |
| Pubmed id:none |
Fluorochromeを用いたchromatin DNAのcolorimetric assay法による単層培養細胞増殖動態の検討 松浦知和 永森静志 藤瀬清隆 蓮村哲 本間定 筋野甫 清水恵一郎 新谷稔 亀田治男 医学のあゆみ 142(13), 957-958 (1987) |
| Pubmed id:none |
樹立ヒト肝癌株細胞中のB型肝炎ウイルスゲノム 藤瀬 清隆, 藤多 和信, 永森 静志, 蓮村 哲, 本間 定, 筋野 甫, 松浦 知和, 清水 恵一郎, 新谷 稔, 大野 典也, 亀田 治男 肝臓 29(5), 697-698 (1988) |
| Images |
|---|
![]() ![]() ![]() ![]() ![]() ![]() ![]() ![]() |
| Movies |
|---|
|
|
LOT Information
生細胞率、増殖速度、細胞濃度はバンクでのロット作製時の実測値として記していますが、保証値ではございません。また、倍加時間は継代間で計測したラフな値です。Viability/Growth rate/Cell number are represented as actual values measured at lot presentation in JCRB, but are not guaranteed values. Additionally, the doubling time is a rough value measured during passages.
| 細胞番号 | JCRB0435 | 細胞名 | |
|---|---|---|---|
| 培養ロット番号 | 04142005 | 培養種別 | distribution |
| 培地 | Eagle's minimal essential medium with 10% fetal bovine serum (FBS lot; GIBCO 4218333S) | 培養温度 | 37 C |
| 継代時細胞数(濃度) | 5 - 15 x 10^4 cells/ml | 継代方法 | 0.25% trypsin and 0.02% EDTA at room temperature for 5 min. |
| 増殖速度 | approx. 40.5 hrs | 凍結時生細胞濃度 | 2.3 x 10^6 |
| 凍結時生細胞率 | 97.1 | 使用抗生物質 | free |
| 継代数 | P17 | PDL数(プライマリ) | |
| マイコプラズマ検出 | - | 細菌汚染検出 | - |
| 真菌汚染検出 | - | アイソザイム検査・動物名 | Confirmed as human by NP, G6PD (type B), MD. |
| 染色体モード | 染色体情報 | ||
| 表面抗原 | DNA Profile (STR) | ||
| 接着性 | Yes | 導入外部遺伝子 | |
| 凍結培地 | 10% DMSO, 20% FBS - Eagle's MEM | 炭酸ガス濃度 | 5% |
| 解凍後生細胞率 | 追加情報 |
| 細胞番号 | JCRB0435 | 細胞名 | JHH-4 |
|---|---|---|---|
| 培養ロット番号 | 061897 | 培養種別 | distribution |
| 培地 | Eagle's minimal essential medium with 10% fetal calf serum (Mitsubishi PVF01). | 培養温度 | 37 C |
| 継代時細胞数(濃度) | 1-2x10^6 cells/sq.cm. | 継代方法 | Cells are harvested after the treatment with 0.25% trypsin and 0.02% EDTA at room temp. for 5 min. |
| 増殖速度 | NT | 凍結時生細胞濃度 | 3.0x10^6 |
| 凍結時生細胞率 | 92.0 | 使用抗生物質 | free |
| 継代数 | P13 | PDL数(プライマリ) | NT |
| マイコプラズマ検出 | - | 細菌汚染検出 | - |
| 真菌汚染検出 | - | アイソザイム検査・動物名 | NT |
| 染色体モード | NT | 染色体情報 | NT |
| 表面抗原 | NT | DNA Profile (STR) | |
| 接着性 | Yes | 導入外部遺伝子 | NT |
| 凍結培地 | Culture mdium with 5% DMSO. | 炭酸ガス濃度 | |
| 解凍後生細胞率 | 追加情報 |
| Images |
|---|
![]() ![]() ![]() ![]() |
| 細胞番号 | JCRB0435 | 細胞名 | JHH-4 |
|---|---|---|---|
| 培養ロット番号 | 04142014 | 培養種別 | distribution |
| 培地 | Eagle's minimal essential medium with 10% fetal calf serum (FBS; GIBCO Cat. # 10091). | 培養温度 | 37 C |
| 継代時細胞数(濃度) | 4.7 - 9.0 x 10^4 cells/mL | 継代方法 | Cells were harvested after the treatment with 0.25% trypsin and 0.02% EDTA. |
| 増殖速度 | 凍結時生細胞濃度 | 2.9 x 10^6 | |
| 凍結時生細胞率 | 96.0 | 使用抗生物質 | free |
| 継代数 | P17 | PDL数(プライマリ) | |
| マイコプラズマ検出 | - | 細菌汚染検出 | - |
| 真菌汚染検出 | - | アイソザイム検査・動物名 | |
| 染色体モード | 染色体情報 | ||
| 表面抗原 | DNA Profile (STR) | D5S818:9,13 D13S317:12 D7S820:10,12 D16S539:12,13 VWA:14,17 TH01:6,9 AM:X TPOX:8,11 CSF1PO:11,12 |
|
| 接着性 | Yes | 導入外部遺伝子 | |
| 凍結培地 | 10% DMSO, 20% FBS - EMEM | 炭酸ガス濃度 | 5% |
| 解凍後生細胞率 | 96.0 | 追加情報 | Cell Bank will handle to get the approval but the depositor may contact to the requester directly. |
| 細胞番号 | JCRB0435 | 細胞名 | JHH-4 |
|---|---|---|---|
| 培養ロット番号 | 01242022 | 培養種別 | distribution |
| 培地 | Eagle's minimum essential medium with 10% fetal bovine serum (FBS; Biowest Cat. # S18200-500) | 培養温度 | 37 C |
| 継代時細胞数(濃度) | 0.4 - 2.0 x 10^5 cells/mL | 継代方法 | Cells were harvested after treatment with 0.25% trypsin and 0.02% EDTA. |
| 増殖速度 | approx. 32 hrs. | 凍結時生細胞濃度 | 1.6 x 10^6 |
| 凍結時生細胞率 | 97 | 使用抗生物質 | free |
| 継代数 | P16 | PDL数(プライマリ) | |
| マイコプラズマ検出 | - | 細菌汚染検出 | - |
| 真菌汚染検出 | - | アイソザイム検査・動物名 | |
| 染色体モード | 染色体情報 | ||
| 表面抗原 | DNA Profile (STR) | ||
| 接着性 | Yes | 導入外部遺伝子 | |
| 凍結培地 | 10% DMSO, 20% FBS - EMEM | 炭酸ガス濃度 | 5% |
| 解凍後生細胞率 | 92 | 追加情報 |